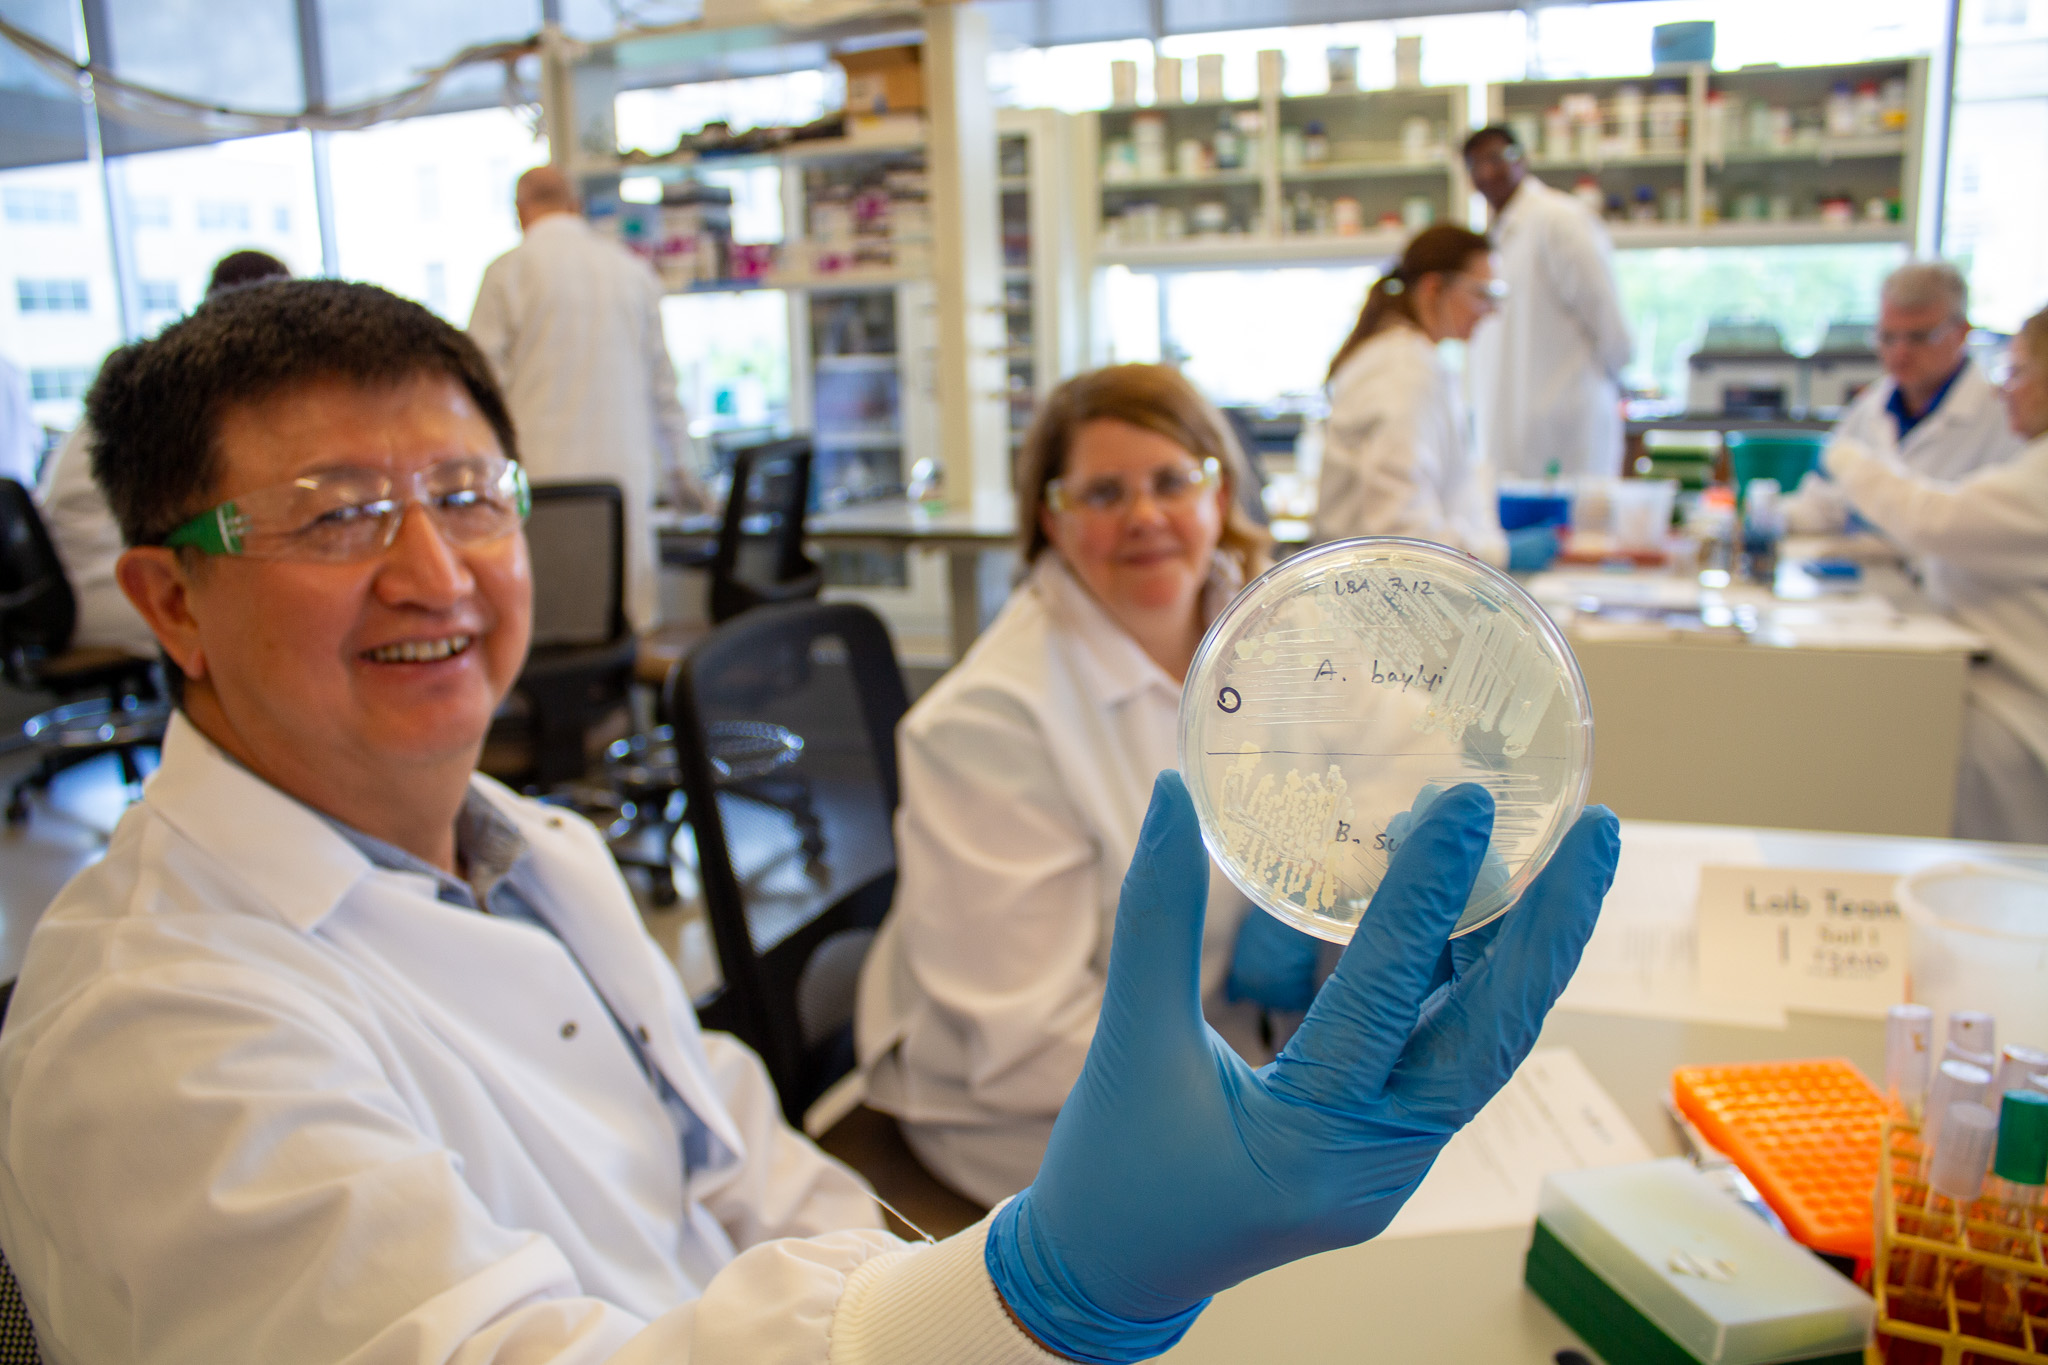

About Tiny Earth
Tiny Earth inspires students to engage in scientific research while addressing some of the most pressing global challenges of our century: the diminishing supply of effective antibiotics, a rapid decline in soil health, and a need for more scientists in the workforce.
Tiny Earth is a course-based undergraduate research experience (CURE), an international network, and an antibiotic discovery pipeline. Tiny Earth’s low-cost curriculum immerses students in the thrill of research. It is supported by an instructor training program that has empowered more than 900 instructors to teach it at institutions ranging from two-year colleges to research universities.
Our long-term vision is for every college student to take a research course such as Tiny Earth. Research courses lead to positive outcomes similar to those of individual student research projects, with the added benefit of being scalable and therefore able to provide research opportunities to dozens or hundreds of students simultaneously.
Our Network
Tiny Earth’s global network has expanded to reach tens of thousands of students enrolled annually in some version of the course. Today, the network spans 33 countries, 46 US states, Puerto Rico, and Washington, D.C. The program is headquartered at the University of Wisconsin–Madison’s Wisconsin Institute for Discovery. The institutional support of a cutting-edge institute at a world-class research university provides a robust foundation for the program’s continued expansion.
Tiny Earth is more than just a course: it is a network of thousands of students and hundreds of instructors share research findings, best practices, and enthusiasm for discovery, including at the community’s annual symposium, local and regional events, and online. The name Tiny Earth reflects the program’s global reach, microscopic subjects, and dynamic community.
Our Roots
From “Microbes to Molecules” to a global community
Tiny Earth as we know it launched in June of 2018, but it truly began six years earlier when Jo Handelsman founded a course–then called “Microbes to Molecules”–at Yale University with a goal of addressing both the antibiotic crisis and the shortage of science trainees.
In short order, the course grew and became a part of a larger initiative until Handelsman returned to the University of Wisconsin–Madison and launched Tiny Earth in collaboration with hundreds of partners worldwide.
Building a STEM Workforce
Authentic research experiences, such as course-based undergraduate research experiences (CUREs), promote student belonging and persistence in science, technology, engineering, and math (STEM) (Bangera & Brownell, 2014; Hanauer et al., 2017; Hurtado et al., 2007; Lopatto et al., 2008). Leveraging the CURE model allows entire classes of students – not just one or two students – to engage in research. Therefore CUREs accelerate the rate of scientific discoveries while increasing the number of students heading into the STEM workforce (Buchanan & Fisher, 2022).
Tiny Earth is a CURE, with a network that includes more than 900 trained instructors in 33 countries who teach a Tiny Earth course to an estimated 18,000+ students per year. The core Tiny Earth curriculum involves soil collection, bacterial isolation and characterization, and assays for potential antimicrobial activity against the safe relatives of known pathogens.
Network Goals
Tiny Earth addresses science education, health, and climate crises through 3 core goals:

Strategic Priorities
We achieve our goals by honing in on four priority areas:

Benefits of Joining the Network
Tiny Earth Partner Instructors:
- Gain a community of instructors and students around the world
- Work with peers toward a common goal
- Discover antibiotics from soil in your backyards
- Present research at international symposiums
- Engage in outreach and social media campaigns
- Participate in ongoing workshops and communities of practice
Advantages of Tiny Earth Scientific Research Course
Throughout the Tiny Earth CURE, students:
- Learn scientific practices and skills
- Develop hypotheses and questions that guide research projects
- Choose soil samples
- Discover antibiotic-producing bacteria
- Practice iteration and repeat experiments
- Develop experimental proficiency
- Hone problem-solving skills
- Empower each other to address a public-health crisis
How does the antibiotic pipeline work?
Collect
Students collect soil and culture bacteria from soil
Test
Students test bacteria for antibiotic activity against safe relatives of pathogens
Extract
Students and research scientists extract chemicals from bacteria with possible antibiotic activity
Analyze
Research scientists at the Tiny Earth Chemistry Hub at UW–Madison analyze genomic and chemical signatures and elucidate bioactive molecules
Further
Scientists in academic and industry labs further test promising molecules in model systems
Market
An antibiotic goes to market to help problem of dwindling supply of effective antibiotics